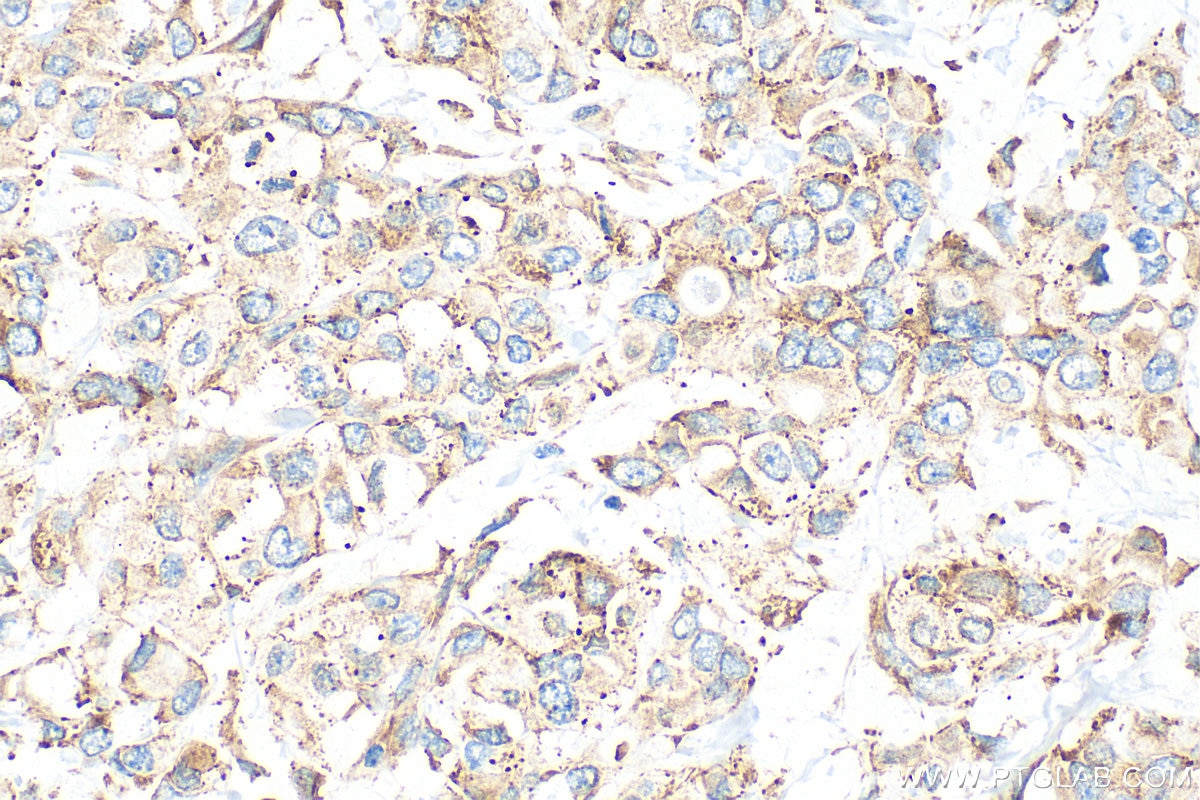
Immunohistochemistry (IHC) staining of human breast cancer tissue using CAPRIN1 Polyclonal antibody (15112-1-AP)

Tested Applications
| Positive WB detected in | HEK-293 cells, mouse brain tissue, HEK-293T cells, HeLa cells, NIH/3T3 cells, rat brain tissue, Jurkat cells |
| Positive IP detected in | HeLa cells |
| Positive IHC detected in | human breast cancer tissue, human prostate cancer tissue, human testis tissue, mouse testis tissue Note: suggested antigen retrieval with TE buffer pH 9.0; (*) Alternatively, antigen retrieval may be performed with citrate buffer pH 6.0 |
| Positive IF/ICC detected in | HeLa cells, sodium arsenite treated HeLa cells, HepG2 cells, OC2 cells, cochlear cryosections |
| Positive FC (Intra) detected in | NIH/3T3 cells |
Recommended dilution
| Application | Dilution |
|---|---|
| Western Blot (WB) | WB : 1:5000-1:50000 |
| Immunoprecipitation (IP) | IP : 0.5-4.0 ug for 1.0-3.0 mg of total protein lysate |
| Immunohistochemistry (IHC) | IHC : 1:500-1:2000 |
| Immunofluorescence (IF)/ICC | IF/ICC : 1:200-1:800 |
| Flow Cytometry (FC) (INTRA) | FC (INTRA) : 0.20 ug per 10^6 cells in a 100 µl suspension |
| It is recommended that this reagent should be titrated in each testing system to obtain optimal results. | |
| Sample-dependent, Check data in validation data gallery. | |
Published Applications
| KD/KO | See 8 publications below |
| WB | See 57 publications below |
| IHC | See 3 publications below |
| IF | See 33 publications below |
| IP | See 6 publications below |
| CoIP | See 2 publications below |
| RIP | See 2 publications below |
Product Information
15112-1-AP targets CAPRIN1 in WB, IHC, IF/ICC, FC (Intra), IP, CoIP, RIP, ELISA applications and shows reactivity with human, mouse, rat samples.
| Tested Reactivity | human, mouse, rat |
| Cited Reactivity | human, mouse, rat, pig, rabbit, canine, monkey, zebrafish |
| Host / Isotype | Rabbit / IgG |
| Class | Polyclonal |
| Type | Antibody |
| Immunogen |
CatNo: Ag7099 Product name: Recombinant human CAPRIN1 protein Source: e coli.-derived, PGEX-4T Tag: GST Domain: 356-709 aa of BC001731 Sequence: RQRVQDLMAQMQGPYNFIQDSMLDFENQTLDPAIVSAQPMNPTQNMDMPQLVCPPVHSESRLAQPNQVPVQPEATQVPLVSSTSEGYTASQPLYQPSHATEQRPQKEPIDQIQATISLNTDQTTASSSLPAASQPQVFQAGTSKPLHSSGINVNAAPFQSMQTVFNMNAPVPPVNEPETLKQQNQYQASYNQSFSSQPHQVEQTELQQEQLQTVVGTYHGSPDQSHQVTGNHQQPPQQNTGFPRSNQPYYNSRGVSRGGSRGARGLMNGYRGPANGFRGGYDGYRPSFSNTPNSGYTQSQFSAPRDYSGYQRDGYQQNFKRGSGQSGPRGAPRGRGGPPRPNRGMPQMNTQQVN Predict reactive species |
| Full Name | cell cycle associated protein 1 |
| Calculated Molecular Weight | 78 kDa |
| Observed Molecular Weight | 116 kDa |
| GenBank Accession Number | BC001731 |
| Gene Symbol | CAPRIN1 |
| Gene ID (NCBI) | 4076 |
| RRID | AB_2070016 |
| Conjugate | Unconjugated |
| Form | Liquid |
| Purification Method | Antigen affinity purification |
| UNIPROT ID | Q14444 |
| Storage Buffer | PBS with 0.02% sodium azide and 50% glycerol, pH 7.3. |
| Storage Conditions | Store at -20°C. Stable for one year after shipment. Aliquoting is unnecessary for -20oC storage. 20ul sizes contain 0.1% BSA. |
Background Information
CAPRIN1 (Caprin-1) is a cytoplasmic phosphoprotein which may regulate the transport and translation of mRNAs of proteins involved in synaptic plasticity in neurons and cell proliferation and migration in multiple cell types. Its levels, except in the brain, are tightly correlated with cellular proliferation. Suppression of expression of human Caprin-1 resulted in slowing of the proliferation rate,which suggests its essential for normal cellular proliferation.
Protocols
| Product Specific Protocols | |
|---|---|
| FC protocol for CAPRIN1 antibody 15112-1-AP | Download protocol |
| IF protocol for CAPRIN1 antibody 15112-1-AP | Download protocol |
| IHC protocol for CAPRIN1 antibody 15112-1-AP | Download protocol |
| IP protocol for CAPRIN1 antibody 15112-1-AP | Download protocol |
| WB protocol for CAPRIN1 antibody 15112-1-AP | Download protocol |
| Standard Protocols | |
|---|---|
| Click here to view our Standard Protocols |
Publications
| Species | Application | Title |
|---|---|---|
Cell In vivo structural characterization of the SARS-CoV-2 RNA genome identifies host proteins vulnerable to repurposed drugs. | ||
Cell Competing Protein-RNA Interaction Networks Control Multiphase Intracellular Organization. | ||
Cell G3BP1 Is a Tunable Switch that Triggers Phase Separation to Assemble Stress Granules.
| ||
Nat Immunol Inducible degradation of lncRNA Sros1 promotes IFN-γ-mediated activation of innate immune responses by stabilizing Stat1 mRNA. | ||
Nat Commun Fear extinction is regulated by the activity of long noncoding RNAs at the synapse | ||
Neuron CYFIP1 coordinates mRNA translation and cytoskeleton remodeling to ensure proper dendritic spine formation. |
Reviews
The reviews below have been submitted by verified Proteintech customers who received an incentive for providing their feedback.
FH Katherine (Verified Customer) (10-31-2023) | The antibody worked well with 1:5000 dilution.
|
FH Lisa (Verified Customer) (02-20-2020) | The antibody works very well, giving specific bands in WB and a very good staining in IF.
![]() |
FH Paul (Verified Customer) (04-30-2019) | Product works very well for WB, IP and IF using rat brain tissue samples.
![]() |